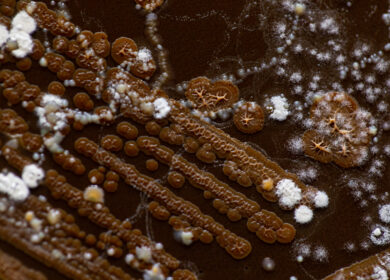

Немецкие ученые изучат вопрос повышения эффективности органического фосфора для домашнего скота

Исследователи из Гогенгеймского университета (г. Штутгарте, Германия) обнаружили, что фосфор, содержащийся в растениях, в процессе переваривания распадается на ряд веществ, мало изученных до недавнего времени, которые, тем не менее, могут благоприятно влиять на здоровье животных.
Фосфор является одним из тех незаменимых элементов, в котором нуждаются как люди, так и животные и растения. Однако именно домашний скот обычно не способен удовлетворить свои потребности в этом элементе только через поедание растительного корма. Тот же фосфор, который фермеры добавляют вручную, добывается из фосфатных руд, природные ископаемые которых конечны, и ряд ученых уже предсказывает так называемый «фосфорный кризис» на планете. Уже в наши дни процесс добычи ископаемого фосфора невероятно трудоемок, а количество фосфатных месторождений во всем мире также весьма ограничено. Качество добываемого фосфора становится все хуже, а его добыча для сельскохозяйственных целей — все сложнее. Европа уже практически не обладает существенными запасами данного химического элемента, и поэтому сельское хозяйство целиком зависит от импортных поставок. По этой причине команда исследователей из Гогенгеймского университета работает над проблемой повышения эффективности фосфора, содержащегося в растительных кормах.
Недавно созданная при Немецком научно-исследовательском обществе (DFG) исследовательская группа «P-FOWL» целью своей работы поставила изучение того, как фосфор, содержащийся в растениях, перерабатывается в пищеварительном тракте кур. Ученых интересовало, как именно можно увеличить эффективность фосфора в животноводстве. Немецкое научно-исследовательское общество выделило около 2 млн. евро на этот проект.
Куры-несушки были выбраны в качестве объекта изучения не зря. Как объясняет профессор Родехтскорд, в процессе своего жизненного цикла оранизм данных птиц претерпевает множество изменений, и его потребность в фосфоре и кальции сильно варьирует на протяжении жизни. Кальций, равно как и фосфор, являются необходимыми веществами для строительства костей и яичной скорлупы. Таким образом, здоровье кур сильно зависит от достаточного количества обоих элементов. В Германии куры-несушки в среднем откладывают до 300 яиц в год. При этом в относительном выражении их потребности в фосфоре значительно превышают таковые у людей. Причиной тому, по мнению профессора Маркуса Родехтскорда (Markus Rodehutscord), является тот факт, что люди вырастают за относительно короткий период своей жизни, после чего их потребности в фосфоре значительно снижаются. У кур-несушек же, напротив, период роста составляет куда большую часть из жизненного цикла, плюс, они постоянно несут яйца, что также повышает потребности организма в фосфоре.
Одной из причин недостаточного количества фосфора, получаемого из растительной пищи, заключается в сложной структуре растительного фосфатного резерва солей фитиновой кислоты (фитата). «В растениях фосфорные элементы связаны в кольцевой структуре, которая должна быть разрушена ферментами в пищеварительном тракте. Пищеварительные системы многих домашних животных, таких как свиньи или домашняя птица, равно как и людей, просто плохо приспособлена для этого.», объясняет Яна Зейферт (Jana Seifert) из Института животноводства Гогенгеймского университета.
Во время проведения предварительного проекта microP стало ясно, что эта особенность пищеварительного тракта является серьезным недостатком. Эксперименты со свиньями показали, что дефицит фосфора отрицательно влияет на отзывчивость иммунной системы. Недостаток нутриента также существенно влияет на гормональный баланс и энергетический обмен.
«Если кишечные микроорганизмы не получают достаточное количество фосфора, они становятся менее эффективными при переработке пищи, и, как следствие, организм получает меньше энергии.», говорит Зейферт.
Текущей задачей команды ученых является определение того, какие бактерии способствуют высвобождению фосфора из связанной формы в процессе переваривания пищи.
«Если нам удасться прояснить роль микроорганизмов, то в долгосрочной перспективе мы можем использовать их для облегчения высвобождения органического фосфора для животных.», считает эксперт по микробиологии.
В процессе высвобождения органического фосфора в пищеварительном тракже образуются различные соединения, одним из которых является мио-инозитол. Несмотря на то, что данные соединения могут влиять на эффективность кишечных бактерий и хорошее самочувствие животных, до настоящего времени они практически не изучались.
«Эксперты по питанию, генетике, микробиоте и физиологии будут работать в исследовательской группе с одними и теми же животными, которые будут содержаться в сельскохозяйственной экспериментальной станции Гогенгеймского университета. Это поможет добиться более точных и сопоставимых результатов», говорит сотрудница университета.
На способность животного извлекать фосфор из растительной пищи также влияет и генетическая предрасположенность. Для более подробного изучения данного вопроса группа ученых получит доступ к образцам экспериментов предыдущих проектов. Помимо этого, в рамках проекта P-FOWL предполагается запустить еще шесть подпроектов, в которых будут изучаться вопросы о том, как именно фосфор извлекается и используется в кишечном тракте, а также как это влияет на метаболизм животных. Группа также имеет поддержку со стороны двух подпроектов в Лейбницком институте биологии домашних животных, расположенном в Думмерсторфе.
Понимание взаимосвязей между генетикой и фосфорным усвоением может впоследствии дать возможность отбирать для спаривания лишь наиболее приспособленных для усвоения фосфора особей, что в результате позволит вывести целые породы животных, наиболее эффективно использующих фосфор в растительном корме, считает профессор Родехтскорд.

Понравилась статья?
Раз в неделю наши подписчики получают сводку актуальных новостей отрасли. Присоединяйтесь и вы!

Обсуждение0 комментариев